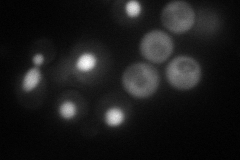
YNL286W
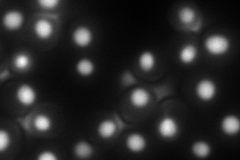
YNL286W
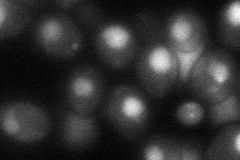
YNL286W
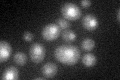
YNL286W
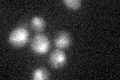
YNL286W

View description
Protein that binds to U2 snRNA and Prp11p, may be involved in U2 snRNA folding; contains two RNA recognition motifs (RRMs)
Localization:
Intensity:
Fold change:
Significance:
-
C’ GFP library in SD

nucleus21.81 -
N' NOP1pr-GFP in SD
nucleus104.348 -
N' TEF2pr-mCherry in SD
nucleus152.832 -
N' NATIVEpr-GFP in SD

cytosol21.5721 -
N' TEF2pr-VC and Cyto-VN in SD
nucleus54.0445 -
C’ GFP library in SD+DTT
nucleus22.311.02No -
C’ GFP library in SD+H2O2
nucleus21.050.96No -
C’ GFP library in Starvation Media

nucleus21.230.97No -
C’ GFP library on the background of Pup2-DaMP

nucleus -
C’ GFP library on the background of CCT mutant

nucleus24.97581.14447No
